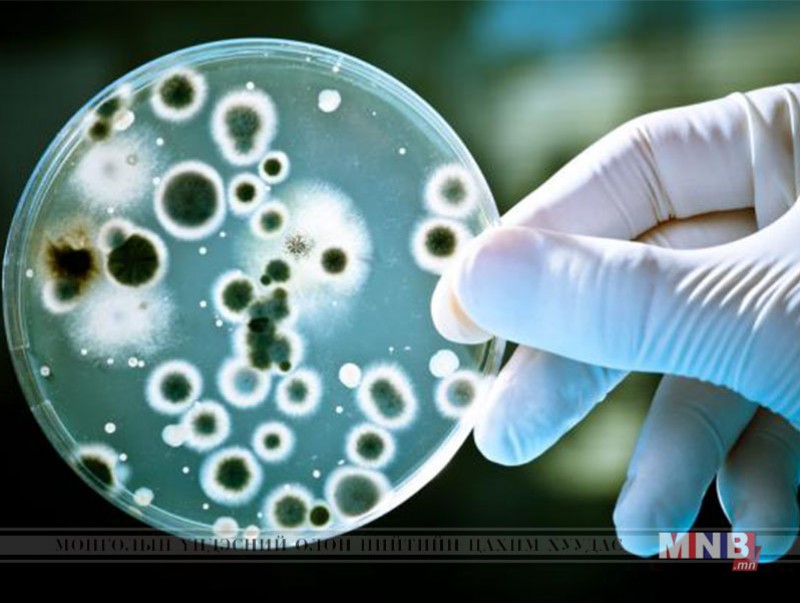

АНУ-ын эрдэмтэд дэлхий дээр байх хамгийн аюултай нянгийн нэгтэй тэмцэх болон харилцан урвалд орж устгах чадвартай антибиотикийг гаргаж авахаар ажиллаж байгаа юм байна.
Тус шинэ төрлийн эм буюу суперантибиотик гэх тодотголыг зүүгээд байгаа шинэ хувилбар нь шинжлэх ухааны салбарт асар том ахиц авчирна хэмээн онцолжээ. Учир нь хуучны хэрэглэж байсан анитибиотиктэй харьцуулахад хор нөлөөгүй төдийгүй үйлчилгээ үзүүлэх чадвараараа хэд дахин илүү гэж эрдэмтэд хэлж байгаа юм. Харин тус эмийн эсрэг хамгийн гол эсэргүүцэх чадвартай хүчин зүйл нь Ванкомицинд тэсвэртэй энтероккок гэдэг нян юм аж.




| Антибиотик хамгийн аюултай нянгуудын нэгтэй тэмцэх болно | ||
| Үзсэн: 1324 | Mongolian National Broadcaster |


 Үндэсний телевиз
Үндэсний телевиз



























































































































 Лханаагийн Мөнхтөр
Лханаагийн Мөнхтөр

 Р.Слава
Р.Слава

 Б.Цоожчулуунцэцэг
Б.Цоожчулуунцэцэг





Сэтгэгдэл бичих:
АНХААРУУЛГА: Уншигчдын бичсэн сэтгэгдэлд MNB.mn хариуцлага хүлээхгүй болно. ТА сэтгэгдэл бичихдээ хууль зүйн болон ёс суртахууны хэм хэмжээг хүндэтгэнэ үү. Хэм хэмжээг зөрчсөн сэтгэгдэлийг админ устгах эрхтэй. Сэтгэгдэлтэй холбоотой санал гомдолыг 70127055 утсаар хүлээн авна.